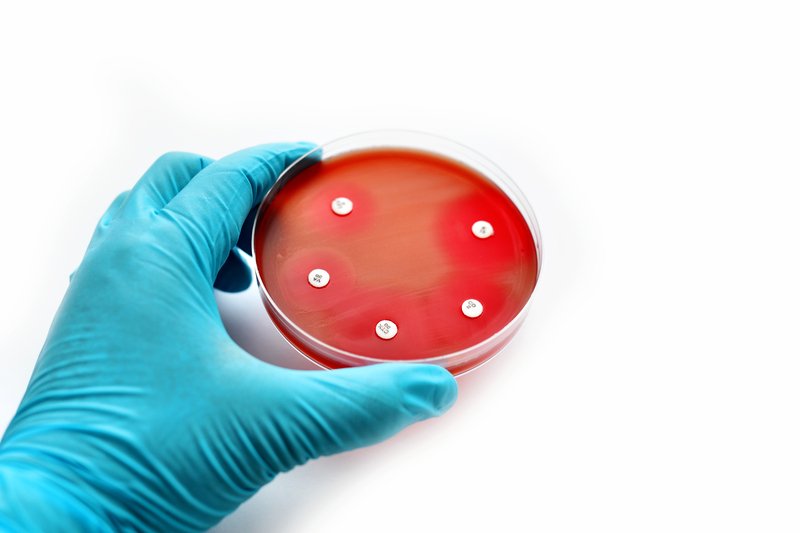
Antibiotico-resistenza

In Italia negli ospedali restano alte le percentuali di resistenza alle principali classi di antibiotici rilevate nei microrganismi ‘sorvegliati’, anche se per alcune combinazioni microrganismo/antibiotico si continua ad osservare un andamento in diminuzione; cresce leggermente la prevalenza dei pazienti con una infezione correlata all’assistenza negli ospedali per acuti, mentre cala dopo il picco pandemico quella nelle terapie intensive. Sono questi i principali andamenti riscontrati dalle diverse sorveglianze e gestite o coordinate dall’Istituto Superiore di Sanità, resi noti nel corso del convegno “L’antibiotico-resistenza in Italia: stato dell’arte e risultati delle rilevazioni 2022-2023 sulle Sorveglianze delle Infezioni Correlate all’Assistenza ICA e dell’Antibiotico-resistenza” che si è tenuto nella sede dell’Iss.
“La raccolta di dati affidabili è il primo passo indispensabile per la risoluzione di qualunque problema medico, e questo vale a maggior ragione per fenomeni complessi come le infezioni correlate all’assistenza e la resistenza agli antibiotici. Questo convegno – ha affermato il Commissario Straordinario dell’Iss Rocco Bellantone in apertura dell’evento – è un’occasione per aumentare la consapevolezza del problema tra gli operatori sanitari e continuare a fare rete per migliorare l’implementazione del Piano Nazionale di contrasto”.
Per elaborare interventi efficaci è necessario implementare la sorveglianza e la ricerca in prospettiva One Health
“Il tema della resistenza agli antibiotici va affrontato nella sua complessità ed è per questo che, nell’organizzazione della giornata, abbiamo voluto toccare alcuni degli aspetti più significativi per mettere a punto interventi efficaci – sottolinea Anna Teresa Palamara, direttrice del dipartimento di Malattie Infettive dell’Iss. Tra questi la sorveglianza, cioè la capacità di tracciare la circolazione dei microrganismi resistenti ed il loro impatto sulla salute, la ricerca in una prospettiva ‘One Health’ che è la base solida su cui si fonda l’innovazione e il progresso tecnologico in campo diagnostico, preventivo e terapeutico; i modelli organizzativi sul territorio, da cui dipende l’attuazione di qualsiasi piano che voglia guidare tutte le attività di contrasto”.
“Il tema della resistenza agli antibiotici non riguarda solo la salute umana, ma va visto in un’ottica ‘One Health’. – ha ricordato il Direttore Generale dell’Iss Andrea Piccioli -. Una prova ulteriore di questa necessità vie e dai risultati preliminari del progetto ‘Sea Care’, coordinato dall’Iss con la Marina Militare. I nostri ricercatori a bordo dell’Amerigo Vespucci e di altre navi della Marina nel corso dei loro campionamenti hanno trovato i geni della resistenza in acque del Mediterraneo, dell’Oceano Atlantico, del Golfo Persico e persino dell’Oceano Artico”.
I dati di Ar-Iss e Cre sui batteri resistenti
In Italia, i dati ottenuti nell’ambito del sistema di sorveglianza nazionale dell’antibiotico-resistenza AR-ISS, condotto dall’Istituto Superiore di Sanità (ISS), che si basa su una rete di laboratori ospedalieri di microbiologia clinica, mostrano che nel 2022 le percentuali di resistenza alle principali classi di antibiotici per gli 8 patogeni sotto sorveglianza in generale si mantengono elevate.
Tuttavia, per alcune combinazioni patogeno/antibiotico, in particolare Klebsiella pneumoniae resistente ai carbapenemi si continua ad osservare un andamento in diminuzione rispetto agli anni precedenti (dal 33,2% nel 2015 al 24,9% nel 2022), mentre per Enterococcus faecium resistente alla vancomicina si osserva un continuo e preoccupante trend in aumento (la percentuale di isolati di resistenti alla vancomicina è passata dall’11,1% del 2015 al 30,7% nel 2022).
I dati della sorveglianza nazionale delle batteriemie da enterobatteri resistenti ai carbapenemi (CRE), condotta dall’ISS, mostrano che, in Italia, nel 2022, sono stati diagnosticati e segnalati circa 3.000 casi, confermando la larga diffusione delle batteriemie da CRE nel nostro paese, soprattutto in pazienti ospedalizzati. Nel 2022 l’incidenza dei casi segnalati è in aumento rispetto al 2021 (3056 casi vs 2396 nel 2021).
Infezioni correlate all’assistenza (ICA) negli ospedali per acuti
A questa sorveglianza, coordinata dall’Iss e condotta dall’università di Torino, hanno partecipato 325 ospedali di 19 Regioni/Province autonome. In totale, sono stati raccolti dati su 60.404 pazienti.
Considerando tutte le ICA, incluse le infezioni da SARS-CoV-2 trasmesse in ospedale, la media della prevalenza di pazienti con ICA nei singoli ospedali era dell’8,8%, mentre nella precedente rilevazione, che si riferisce al 2017, era dell’8,1%.
Su un totale di 6.340 ICA registrate, le tre tipologie di ICA riscontrate con maggior frequenza erano: infezioni del basso tratto respiratorio (19,18%), infezioni del sangue (18,83%), infezioni delle vie urinarie (17,09%), COVID-19 (16,23%), infezioni del sito chirurgico (10,53%).
Tra i vari fattori che incidono sulla prevalenza si segnalano la Regione/PA partecipante (dal 4,17% al 14,14%; le dimensioni dell’ospedale: 7,81%, 8,83% e 12,20% rispettivamente per ospedali piccoli (< 200 posti letto per acuti), medi (201 – 500 posti letto) e grandi (≥ 500 posti letto); la classe di età: dal 4,21% in età neonatale/pediatrica (≤ 18 anni) all’11,71% negli adulti sopra i 65 anni;
Infezioni correlate all’assistenza nelle Unità di Terapia intensiva
Sono stati presentati i risultati della nona edizione (2022-2023) del Progetto SPIN-UTI – Sorveglianza attiva Prospettica delle Infezioni Nosocomiali nelle Unità di Terapia Intensiva (UTI), del Gruppo Italiano Studio Igiene Ospedaliera (GISIO) della Società Italiana di Igiene, Medicina Preventiva e Sanità pubblica (SItI). Nel corso di quest’ultima edizione, la sorveglianza ha incluso circa 4200 pazienti degenti in più di 60 UTI su tutto il territorio nazionale, da ottobre 2022 a luglio 2023.
Dopo il picco del 24,5% osservato nella scorsa edizione 2020-21, l’incidenza di pazienti infetti diminuisce al 18,8% nel 2022-2023, così come l’incidenza di infezioni correlate all’assistenza (ICA) che diminuisce da 30,6 a 29,3 ICA per 100 pazienti. Analogamente, anche la mortalità in UTI ritorna sui livelli pre-pandemici (26,8% nel 2022-2023) rispetto al picco osservato nella precedente edizione 2020-21 (42,3%).
Per quanto concerne l’antimicrobico-resistenza, sebbene non vi siano variazioni nella proporzione di isolati multidrug-resistant (MDR) tra tutti gli isolati associati a ICA, un significativo trend in aumento è evidente per l’incidenza di ICA da A. baumannii MDR (5,4 per 100 pazienti nel 2022-2023) e per l’incidenza di ICA da K. pneumoniae MDR (5,1 per 100 pazienti).
Lo strumento Spincar-1 per monitorare le azioni di contrasto
Lo strumento SPiNCAR-1 è stato sviluppato per monitorare l’implementazione delle azioni di contrasto all’AMR a livello regionale e di struttura assistenziale.
La prima raccolta dei dati si riferisce al 2022 ed è durata da giugno a novembre 2023 attraverso un questionario via web con più di 200 domande multidisciplinare suddivise in aree tematiche in cui vengono definiti degli standard.
14 tra Regioni/P.A. e 130 Strutture hanno partecipato alla rilevazione volontaria.
L’analisi preliminare dei risultati ha evidenziato una realtà variegata sia tra le diverse istituzioni, sia per le differenti aree tematiche del questionario.
Riguardo quest’ultime i risultati migliori, ad esempio, sono nell’area “Uso Appropriato degli Antibiotici”, in cui più dell’80% degli Enti coinvolti che ha dichiarato di aver adottato politiche di contenimento della prescrizione di antimicrobici, oppure nell’area “Sorveglianza”, in cui il 75% dei rispondenti ha dichiarato di disporre di un sistema di sorveglianza delle resistenze agli antimicrobici in ambito umano.
Per altri standard, come ad esempio nell’area “Alleanza per il contrasto all’antimicrobico-resistenza” appare necessario un maggiore impegno; ad esempio, meno del 25% degli Enti ha raggiunto gli standard inerenti all’adozione di iniziative per il coinvolgimento attivo e la formazione di cittadini/pazienti sul tema del contrasto all’antimicrobico-resistenza, uso appropriato degli antimicrobici e prevenzione e controllo delle ICA.
Il consumo di soluzione idroalcolica negli ospedali
In Italia dal 2021 è attiva la Sorveglianza nazionale del Consumo di Soluzione Idro-Alcolica (CSIA) gestita dall’ISS per l’igiene delle mani in ambito ospedaliero.
Ad oggi sono stati raccolti i dati relativi agli anni 2020, 2021 e 2022 da rispettivamente 13, 11 e 16 Regioni/PP.AA.
Nel 2022 si riscontra una ulteriore riduzione dei consumi mediani nazionali di soluzione idroalcolica, arrivati a 15,63 Litri/1.000 Giornate di Degenza Ordinaria (GDO), mentre era 20,66 nel 2021 e 24,47 nel 2020 a fronte di uno standard di 20 litri/1.000 giornate di degenza.